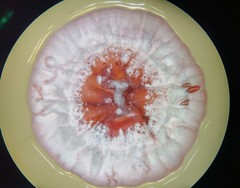
Streptomyces

Streptomyces: taxon details and analytics
- Domain
- Kingdom
- Bacteria
- Phylum
- Actinobacteria
- Class
- Order
- Actinomycetales
- Family
- Streptomycetaceae
- Genus
- Streptomyces
- Species
- Scientific Name
- Streptomyces
Summary description from Wikipedia:
Streptomyces
Streptomyces, from στρεπτός (streptós), meaning "twisted", and μύκης (múkés), meaning "fungus", is the largest genus of Actinomycetota, and the type genus of the family Streptomycetaceae. Over 700 species of Streptomyces bacteria have been described. As with the other Actinomycetota, streptomycetes are gram-positive, and have very large genomes with high GC content. Found predominantly in soil and decaying vegetation, most streptomycetes produce spores, and are noted for their distinct "earthy" odor that results from production of a volatile metabolite, geosmin. Different strains of the same species may colonize very diverse environments.
Streptomycetes are characterised by a complex secondary metabolism. Between 5-23% (average: 12%) of the protein-coding genes of each Streptomyces species are implicated in secondary metabolism. Streptomycetes produce over two-thirds of the clinically useful antibiotics of natural origin (e.g., neomycin, streptomycin, cypemycin, grisemycin, bottromycins and chloramphenicol). The antibiotic streptomycin takes its name directly from Streptomyces. Streptomycetes are infrequent pathogens, though infections in humans, such as mycetoma, can be caused by S. somaliensis and S. sudanensis, and in plants can be caused by S. caviscabies, S. acidiscabies, S. turgidiscabies and S. scabies.
...Images from inaturalist.org observations:
We recommend you sign up for this excellent, free service.
Parent Taxon
Sibling Taxa
Child Taxa
- Streptomyces acidiscabies
- Streptomyces alfalfae
- Streptomyces atroolivaceus
- Streptomyces chumphonensis
- Streptomyces diastaticus
- Streptomyces endophyticus
- Streptomyces endosymbiont of venustus
- Streptomyces flavotricini
- Streptomyces flavoviridis
- Streptomyces griseus
- Streptomyces hirsutus
- Streptomyces intermedius
- Streptomyces lanatus
- Streptomyces microflavus
- Streptomyces psammoticus
- Streptomyces rochei
- Streptomyces roseogriseus
- Streptomyces scabies
- Streptomyces similanensis
- Streptomyces violaceus